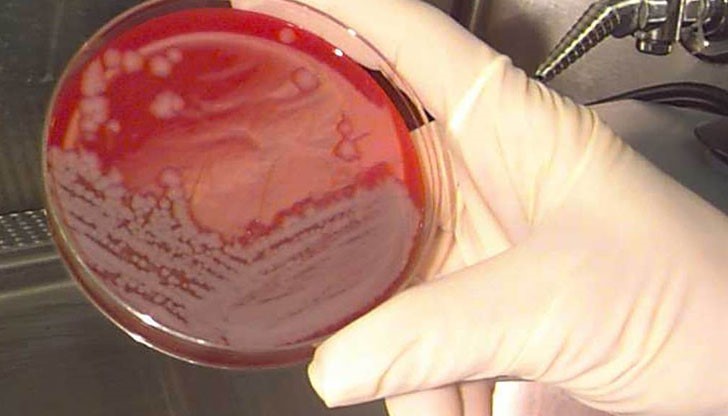
Областният управител апелира към представителите на МВР да засилят контрола върху всеки един транспорт с живи животни Областният управител апелира към представителите на МВР да засилят контрола върху всеки един транспорт с живи животни

Засилени мерки срещу разпространението на бруцелоза в русенско
- Редактор: Виктор Тошев
- Коментари: 0
Днес, Областният управител на Област Русе Стефко Бурджиев и неговият заместник Станимир Станчев проведоха работна среща свързана с набелязването на мерки във връзка с усложнената епизоотична обстановка по отношение на болестта бруцелоза по овцете и козите, разпространена поради нерегламентирано превозване на животни. Участие взеха д-р Андриан Райков – директор на ОДБХ – Русе, д-р Николай Ненов – официален ветеринарен лекар на Община Русе, представители на ОД на МВР – Русе и Регионална дирекция автомобилна инспекция – Русе.
В началото на срещата д-р Райков подчерта, че най-важното което трябва да се направи сега за нашата област е да се набележат конкретни мерки, които да ограничат появата и разпространението на заболяването. Действията трябва да бъдат бързи и ефективни, точно за това от днес започват и срещи с кметовете на населените места в русенска област, каза д-р Райков. Целта е да сигнализират, ако има констатиране на придвижване на животни без необходимата маркировка по закон и липса на документи и да бъдат задържани за временно пребиваване на територията на съответната община до следващ етап, когато трябва да се транспортират до кланици.
Д-р Николай Ненов подробно описа симптомите на заболяването бруцелоза. Той заяви, че тя представлява зооноза, т.е развива се и при животни и при хора. При хората това става основно при консумация на сурови животински продукти, като мляко, млечни продукти и месо. По този повод профилактиката е от особено значение. Заболелите животни от бруцелоза се изолират и унищожават. Това заболяване не е констатирано близо 70 години в България, подчерта още д-р Ненов.
По време на срещата беше уточнено, че всички животновъди са задължени да идентифицират животните и да спазват всички забрани от закона. Движението на животни на територията на страната се извършва чрез лицензиран превоз, като лиценза се издава по заявка от Българската агенция по безопасност на храните.
В момента заболели животни има на територията на Плевенска област и е изключително важно да се спазва стриктно регламента с транспортиране на животни за да не се допусне заболяването да бъде пренесено в нашата област, подчерта д-р Андриан Райков.
От своя страна Областният управител Стефко Бурджиев апелира към представителите на ОД на МВР и Регионалната дирекция автомобилна инспекция – Русе да засилят контрола върху всеки един транспорт с живи животни. Да се правят необходимите проверки и да бъдат изисквани всички съпътстващи документи. Губернаторът направи предложение да бъдат уведомени и представителите на Регионална дирекция „Гранична полиция” и да им бъде предоставен пълен набор от документи по който, стриктно да следят за трансграничния превоз на живи животни и по този начин да не бъде допускано разпространението на заболяването.
























Младежите обявиха война на модела "Борисов – Пеевски"
Младежите обявиха война на модела "Борисов – Пеевски"
Християн Мицкоски: Няма да отстъпим пред България нито...
Младежите обявиха война на модела "Борисов – Пеевски"
Приятел на прегазеното от влак момче се опитал да го спаси в...